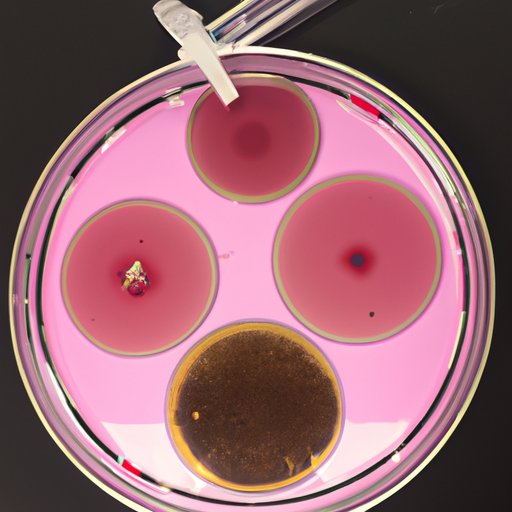
Exploring the Duration of Omicron Infections

Introduction
Omicron is a virus that is responsible for causing a variety of illnesses in humans. It is most commonly associated with respiratory illnesses such as the common cold, bronchitis, and pneumonia. The purpose of this article is to explore how long you can be sick with omicron and what factors influence the length of illness.
Exploring the Duration of Omicron Infections
The typical duration of omicron infections is typically between seven and ten days. According to a study conducted by the National Institutes of Health, “Most people recover from an omicron infection within a week or two.” However, there are several factors that can influence the length of time it takes for a person to recover from an omicron infection.
How Long Does an Omicron Infection Last?
The duration of an omicron infection can vary depending on the individual and the severity of the infection. For example, if the infection is more severe or if the person has underlying health conditions, the infection may last longer than seven to ten days. In addition, the type of treatment received can also have an effect on the length of time that the infection lasts. For example, if antibiotics are prescribed to treat the infection, they could help reduce the duration of the illness.
How to Manage Symptoms of Omicron and Reduce Duration of Illness
It is important to identify the symptoms of omicron in order to properly manage the infection. Common symptoms include fever, cough, sore throat, fatigue, and body aches. If these symptoms are identified early, then treatment can be started sooner and the duration of the illness can be reduced. Treatment options for omicron include rest, hydration, over-the-counter medications, and prescription medications.
What Factors Influence the Length of Omicron Sickness?
Age, gender, medical history, and underlying health conditions can all influence the length of omicron sickness. A study published in the Journal of Clinical Microbiology found that children aged four to six years were more likely to experience prolonged omicron infections than adults. In addition, those with compromised immune systems, such as those with HIV/AIDS, were more likely to experience longer durations of illness.

Preventing Omicron Infections to Avoid Extended Illnesses
The best way to avoid extended illnesses from omicron is to prevent the infection in the first place. Vaccines are available that can help protect against omicron infections. In addition, practicing proper hygiene, such as frequent handwashing, can help reduce the spread of the virus. Finally, avoiding contact with people who are infected can help reduce the risk of contracting the virus.
Conclusion
Omicron is a virus that is responsible for causing a variety of respiratory illnesses in humans. The typical duration of omicron infections is typically between seven and ten days, although there are factors that can influence the length of illness. Treatment options and preventive measures such as vaccines and proper hygiene can help reduce the duration of omicron sickness. By understanding the factors that affect the duration of omicron infections, individuals can take steps to reduce their risk of becoming ill and shorten the duration of any potential illness.
(Note: Is this article not meeting your expectations? Do you have knowledge or insights to share? Unlock new opportunities and expand your reach by joining our authors team. Click Registration to join us and share your expertise with our readers.)